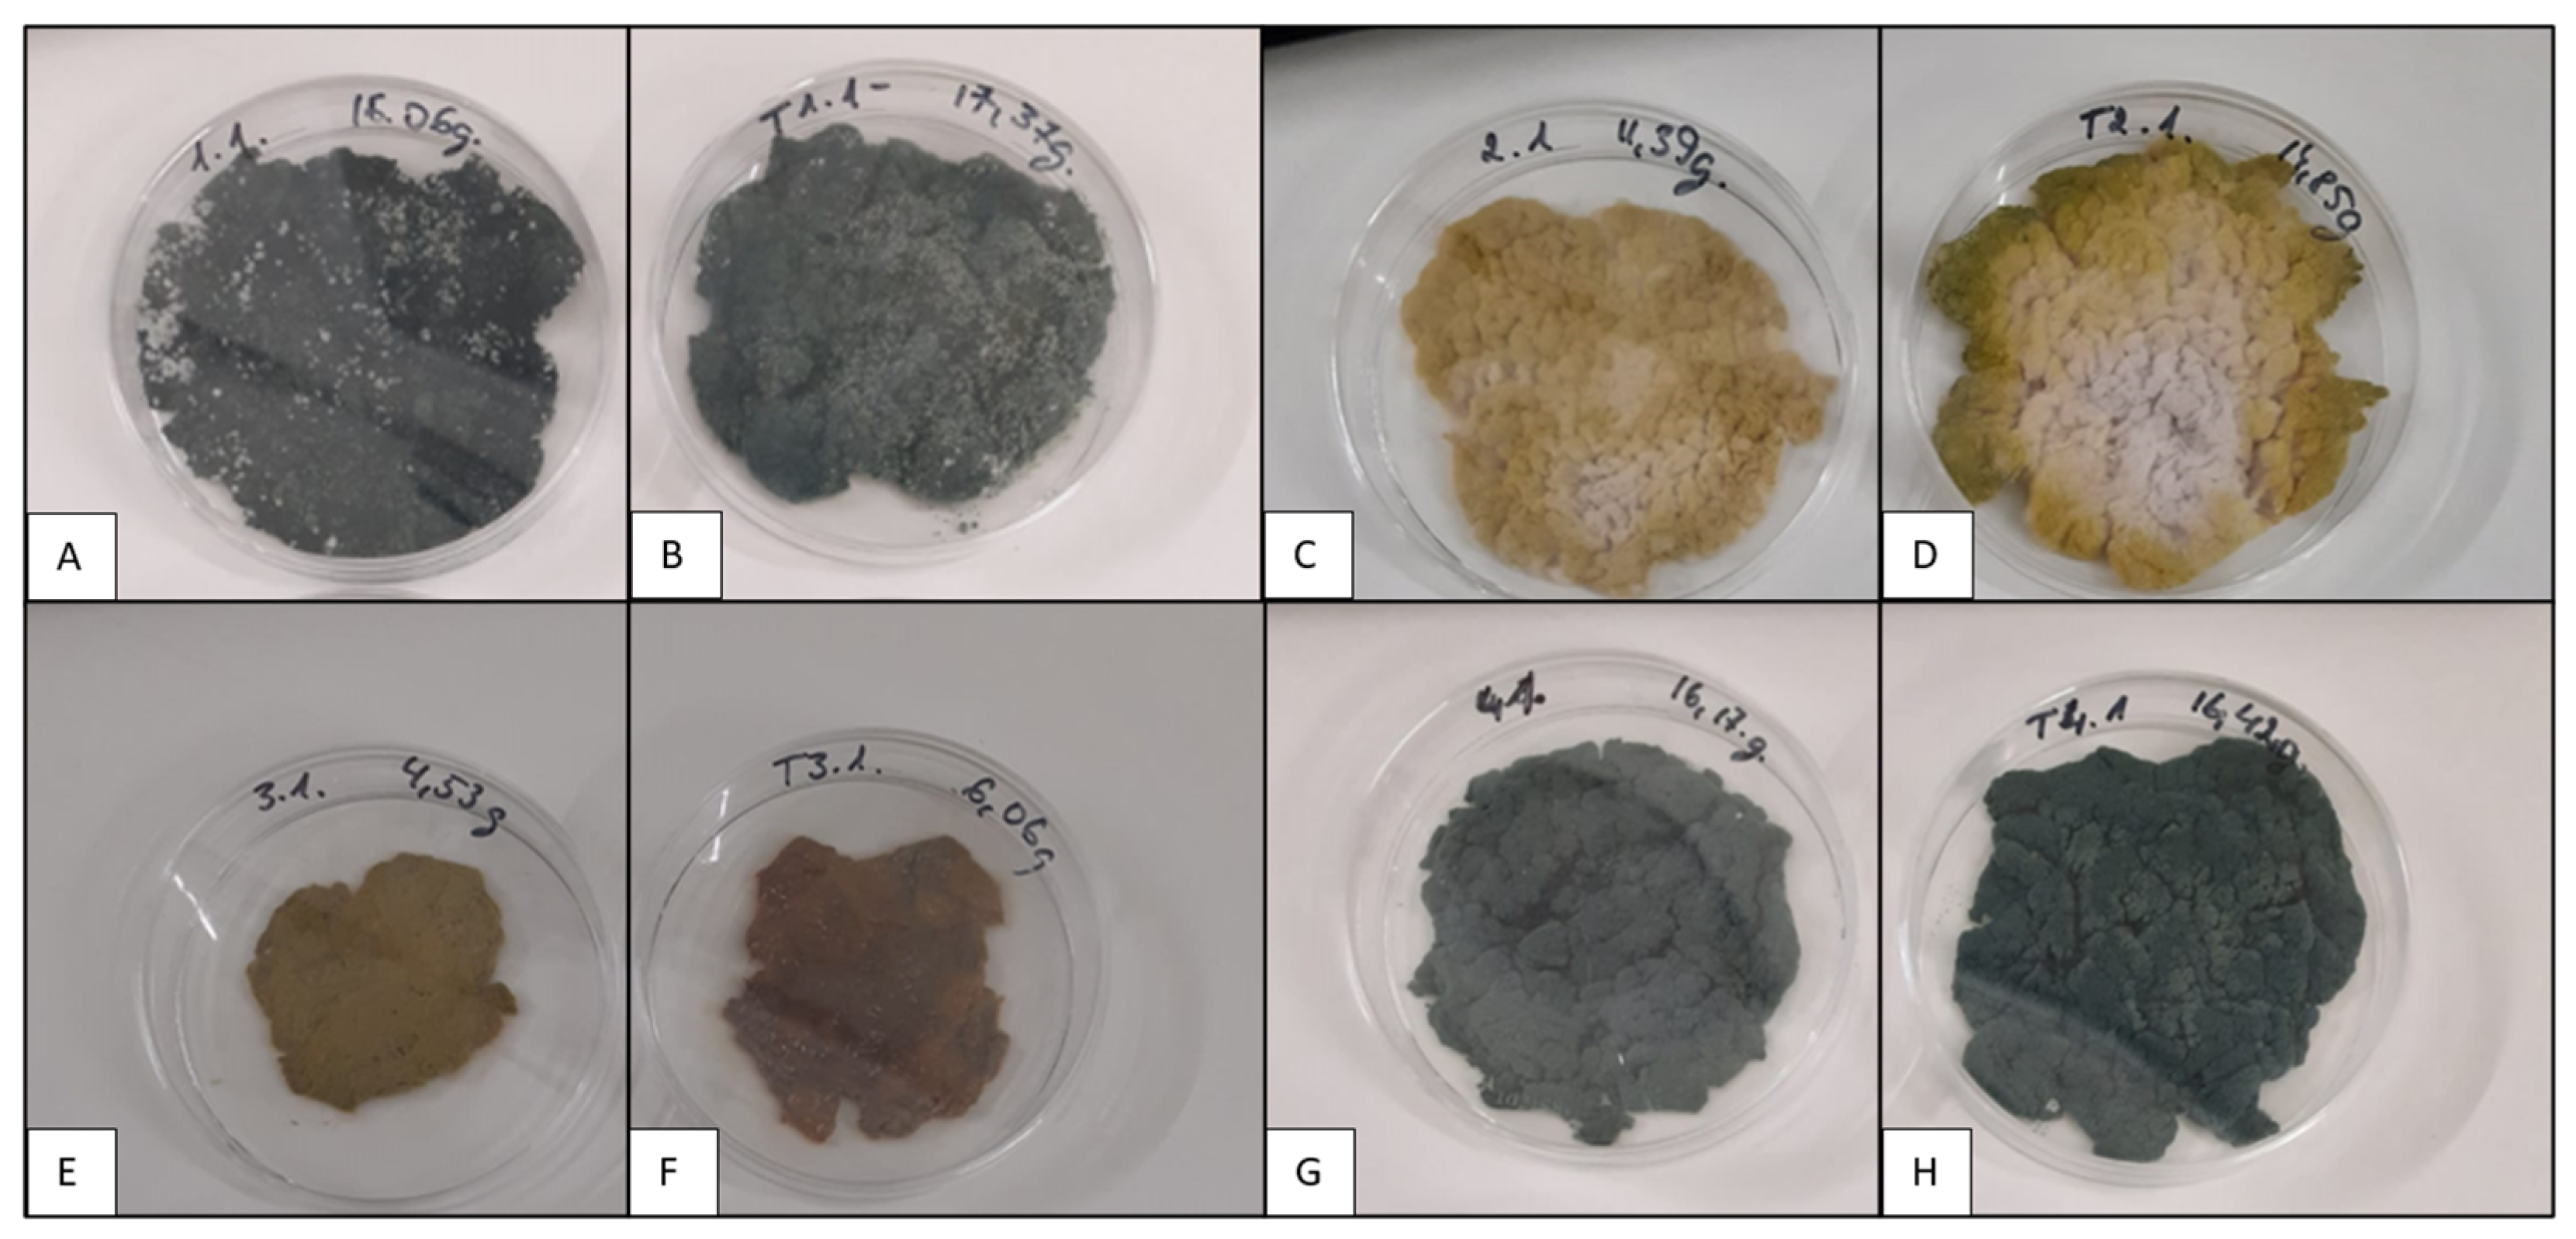
Microorganisms 11 01084 g002 Microorganisms 11 01084 g002
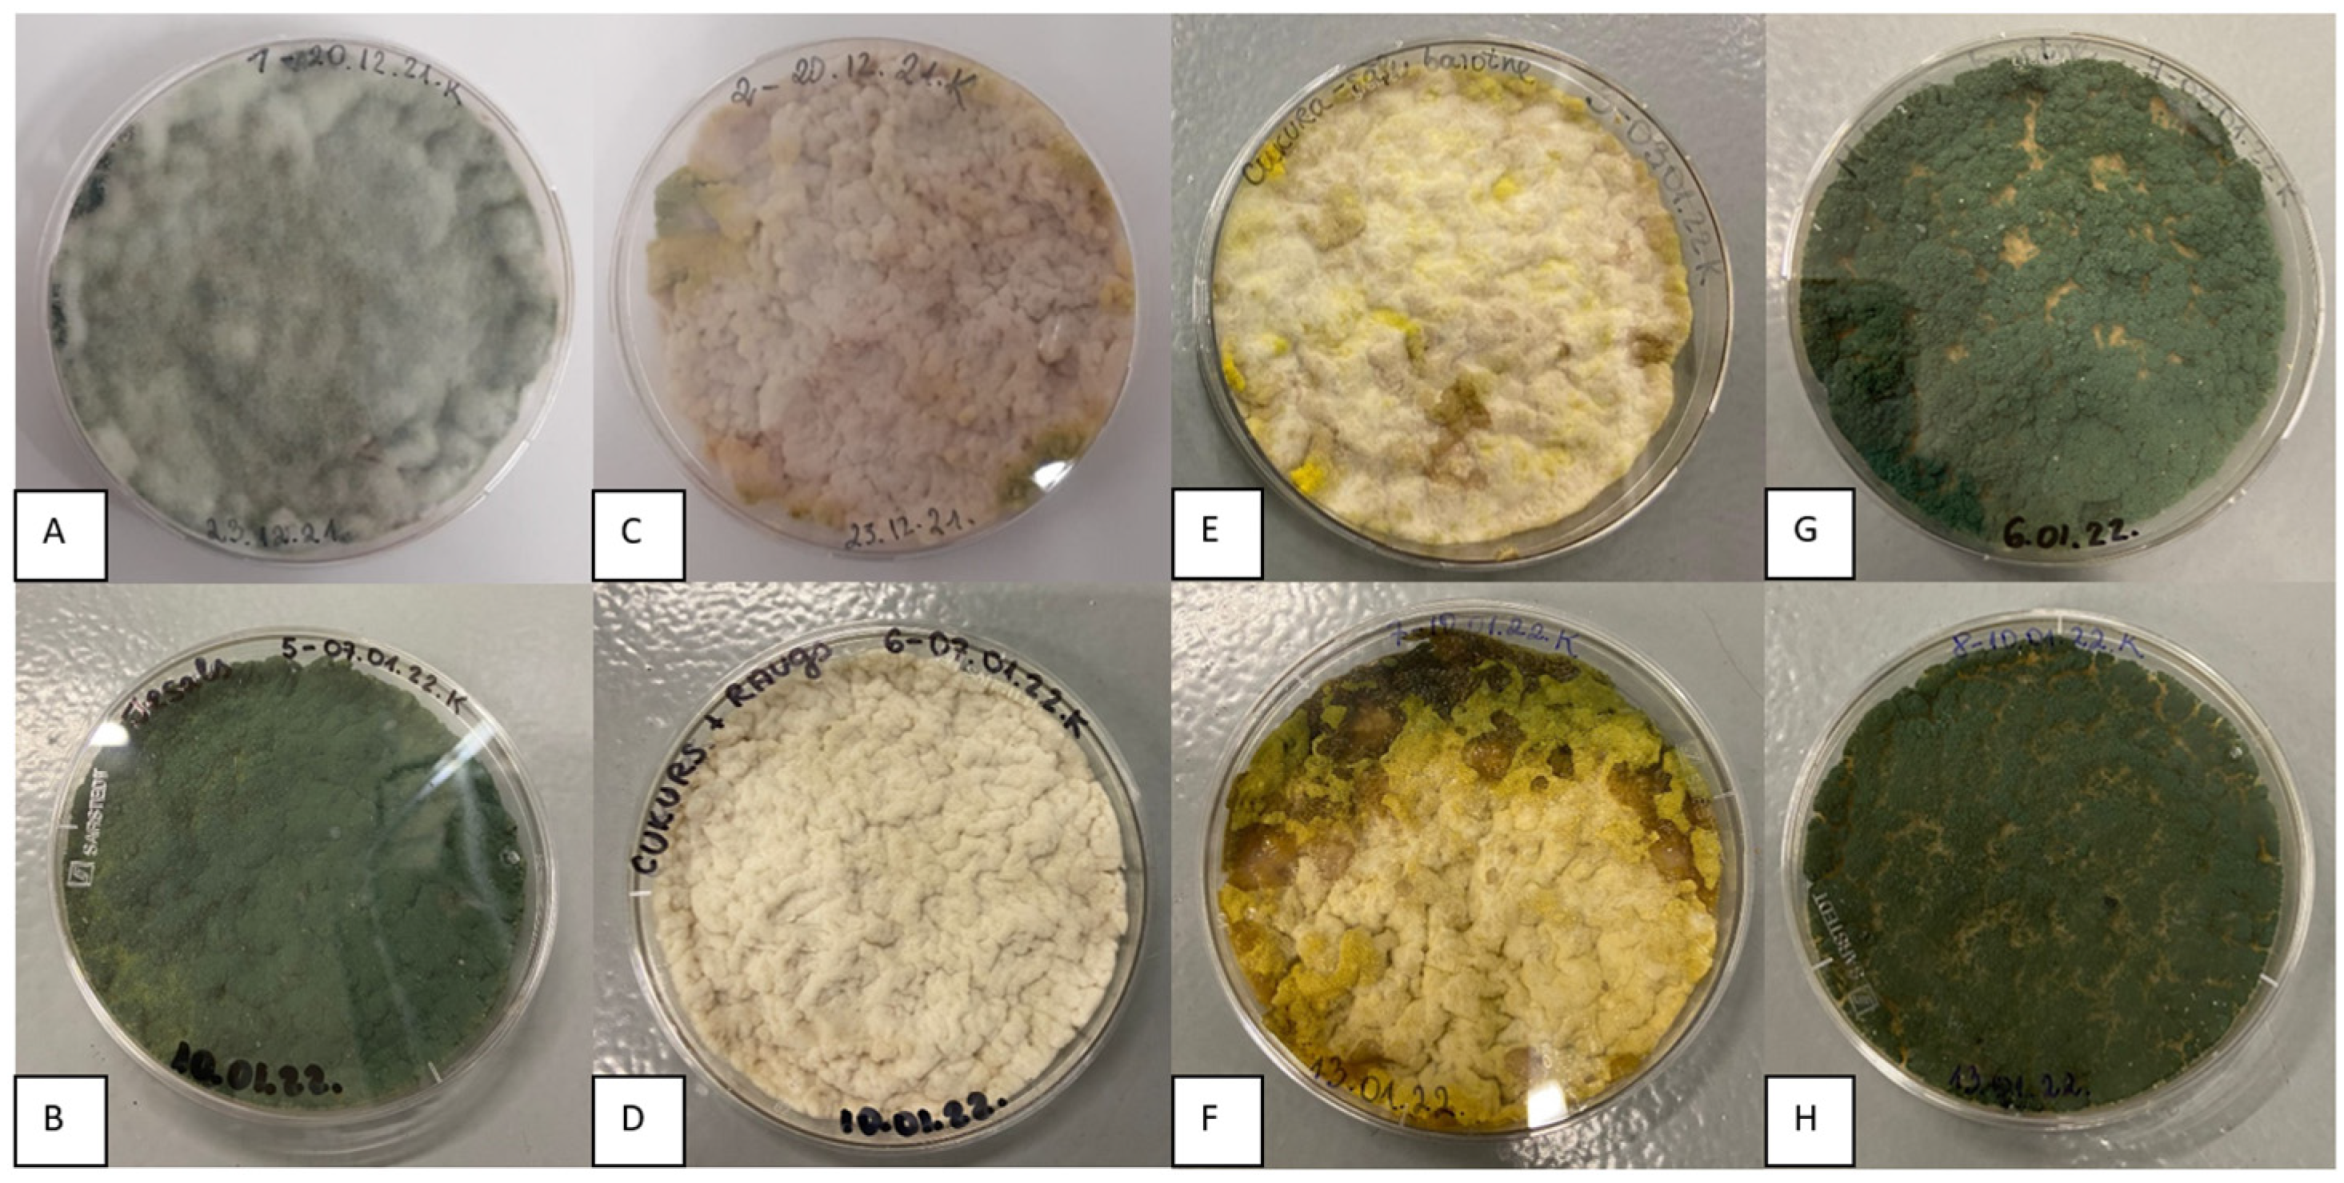
Microorganisms 11 01084 g004 Microorganisms 11 01084 g004

Impact of Growth Conditions on the Viability of Trichoderma asperellum during Storage
Abstract
1. Introduction
2. Materials and Methods
2.1. Maintenance of the Culture and Media Used
2.2. Trichoderma asperellum Cultivation in Shake Flasks
2.3. Trichoderma asperellum Cultivation in a Bioreactor
2.4. Storage of T. asperellum in Peat
2.5. Analytical Measurements
2.6. Statistical Data Processing and Analysis
3. Results
3.1. Trichoderma asperellum Biomass Cultivation in Shake Flasks and Storage Tests
3.2. Trichoderma asperellum Biomass Cultivation in a Bioreactor and Storage Tests
4. Discussion
5. Conclusions
Author Contributions
Funding
Data Availability Statement
Conflicts of Interest
References
- Dubey, S.C.; Suresh, M.; Singh, B. Evaluation of Trichoderma Species against Fusarium oxysporum f. Sp. Ciceris for Integrated Management of Chickpea Wilt. Biol. Control 2007, 40, 118–127. [Google Scholar] [CrossRef]
- Hermosa, R.; Viterbo, A.; Chet, I.; Monte, E. Plant-Beneficial Effects of Trichoderma and of Its Genes. Microbiology 2012, 158, 17–25. [Google Scholar] [CrossRef]
- Prakash, V.; Basu, K. Mass Multiplication of Trichoderma in Bioreactors. In Trichoderma: Agricultural Applications and Beyond; Manoharachary, C., Singh, H.B., Varma, A., Eds.; Springer International Publishing: Cham, Switzerland, 2020; pp. 113–126. ISBN 978-3-030-54758-5. [Google Scholar] [CrossRef]
- Ramanujam, B.; Prasad, R.D.; Sriram, S.; Rangeswaran, R. Mass Production, Formulation, Quality Control and Delivery of Trichoderma for Plant Disease Management. J. Plant Prot. Sci. 2010, 2, 1–8. [Google Scholar]
- Onilude, A.A.; Adebayo-Tayo, B.C.; Odeniyi, A.O.; Banjo, D.; Garuba, E.O. Comparative Mycelial and Spore Yield by Trichoderma viride in Batch and Fed-Batch Cultures. Ann. Microbiol. 2013, 63, 547–553. [Google Scholar] [CrossRef]
- Muñoz, G.A.; Agosin, E.; Cotoras, M.; Martin, R.S.; Volpe, D. Comparison of Aerial and Submerged Spore Properties for Trichoderma harzianum. FEMS Microbiol. Lett. 1995, 125, 63–69. [Google Scholar] [CrossRef]
- Zaki, O.; Weekers, F.; Thonart, P.; Tesch, E.; Kuenemann, P.; Jacques, P. Limiting Factors of Mycopesticide Development. Biol. Control 2020, 144, 104220. [Google Scholar] [CrossRef]
- Agosin, E.; Volpe, D.; Mun~oz, G.; San Martin, R.; Crawford, A. Effect of Culture Conditions on Spore Shelf Life of the Biocontrol Agent Trichoderma harzianum. World J. Microbiol. Biotechnol. 1997, 13, 225–232. [Google Scholar] [CrossRef]
- Stracquadanio, C.; Quiles, J.M.; Meca, G.; Cacciola, S.O. Antifungal Activity of Bioactive Metabolites Produced by Trichoderma asperellum and Trichoderma atroviride in Liquid Medium. J. Fungi 2020, 6, 263. [Google Scholar] [CrossRef]
- Elzein, A.; Kroschel, J.; Müller-Stöver, D. Effects of Inoculum Type and Propagule Concentration on Shelf Life of Pesta Formulations Containing Fusarium oxysporum Foxy 2, a Potential Mycoherbicide Agent for Striga Spp. Biol. Control 2004, 30, 203–211. [Google Scholar] [CrossRef]
- Friesen, T.J.; Holloway, G.; Hill, G.A.; Pugsley, T.S. Effect of Conditions and Protectants on the Survival of Penicillium Bilaiae during Storage. Biocontrol Sci. Technol. 2006, 16, 89–98. [Google Scholar] [CrossRef]
- Connick, W.J.; Daigle, D.J.; Boyette, C.D.; Williams, K.S.; Vinyard, B.T.; Quimby, P.C. Water Activity and Other Factors That Affect the Viability of Colletotrichum Truncatum Conidia in Wheat Flour-Kaolin Granules (‘Pesta’). Biocontrol Sci. Technol. 1996, 6, 277–284. [Google Scholar] [CrossRef]
- Šimkovič, M.; Ditte, P.; Kurucová, A.; Lakatoš, B.; Varečka, L. Ca2+-Dependent Induction of Conidiation in Submerged Cultures of Trichoderma viride. Can. J. Microbiol. 2008, 54, 291–298. [Google Scholar] [CrossRef] [PubMed]
- Kolombet, L.; Zhigletsova, S.; Kosareva, N.; Bystrova, E.; Derbyshev, V.; Krasnova, S.; Schisler, D. Development of an Extended Shelf-Life, Liquid Formulation of the Biofungicide Trichoderma asperellum. World J. Microbiol. Biotechnol. 2008, 24, 123–131. [Google Scholar] [CrossRef]
- de Rezende, L.C.; de Andrade Carvalho, A.L.; Costa, L.B.; de Almeida Halfeld-Vieira, B.; Silva, L.G.; Pinto, Z.V.; Morandi, M.A.B.; de Medeiros, F.H.V.; Mascarin, G.M.; Bettiol, W. Optimizing Mass Production of Trichoderma asperelloides by Submerged Liquid Fermentation and Its Antagonism against Sclerotinia Sclerotiorum. World J. Microbiol. Biotechnol. 2020, 36, 113. [Google Scholar] [CrossRef]
- Lucatero, S.; Galindo, E.; Larralde-Corona, C.P. Quantitative Characterisation of the Morphology of Trichoderma harzianum Cultured in Shake-Flasks and Containing Tween 40. Biotechnol. Lett. 2004, 26, 41–44. [Google Scholar] [CrossRef]
- Liu, Y.-S.; Wu, J.-Y. Effects of Tween 80 and PH on Mycelial Pellets and Exopolysaccharide Production in Liquid Culture of a Medicinal Fungus. J. Ind. Microbiol. Biotechnol. 2012, 39, 623–628. [Google Scholar] [CrossRef]
- Panda, T.; Gruber, H.; Kubicek, C.P. Stimulation of Protein Secretion in Trichoderma reesei by Tween Surfactants Is Not Correlated with Changes in Enzyme Localization or Membrane Fatty Acid Composition. FEMS Microbiol. Lett. 1987, 41, 85–90.19. [Google Scholar] [CrossRef]
- Ma, X.-K.; Zhang, H.; Fam, H. Influence of Rutin, FeSO4, Tween 80, Aspartate and Complex Vitamins on Synthesis of Fungal Exopolysaccharide. Carbohydr. Polym. 2013, 92, 1188–1196. [Google Scholar] [CrossRef]
- Zhang, B.-B.; Chen, L.; Cheung, P.C.K. Proteomic Insights into the Stimulatory Effect of Tween 80 on Mycelial Growth and Exopolysaccharide Production of an Edible Mushroom Pleurotus Tuber-Regium. Biotechnol. Lett. 2012, 34, 1863–1867. [Google Scholar] [CrossRef]
- Harman, G.E.; Jin, X.; Stasz, T.E.; Peruzzotti, G.; Leopold, A.C.; Taylor, A.G. Production of Conidial Biomass of Trichoderma harzianum for Biological Control. Biol. Control 1991, 1, 23–28. [Google Scholar] [CrossRef]
- Cumagun, C.J.R. Chapter 39—Advances in Formulation of Trichoderma for Biocontrol. In Biotechnology and Biology of Trichoderma; Gupta, V.K., Schmoll, M., Herrera-Estrella, A., Upadhyay, R.S., Druzhinina, I., Tuohy, M.G., Eds.; Elsevier: Amsterdam, The Netherlands, 2014; pp. 527–531. ISBN 978-0-444-59576-8. [Google Scholar]
- Zhang, F.; Huo, Y.; Cobb, A.B.; Luo, G.; Zhou, J.; Yang, G.; Wilson, G.W.T.; Zhang, Y. Trichoderma Biofertilizer Links to Altered Soil Chemistry, Altered Microbial Communities, and Improved Grassland Biomass. Front. Microbiol. 2018, 9, 848. [Google Scholar] [CrossRef] [PubMed]
- Doni, F.; Isahak, A.; Che Mohd Zain, C.R.; Mohd Ariffin, S.; Wan Mohamad, W.N.; Wan Yusoff, W.M. Formulation of Trichoderma Sp. SL2 Inoculants Using Different Carriers for Soil Treatment in Rice Seedling Growth. SpringerPlus 2014, 3, 532. [Google Scholar] [CrossRef] [PubMed]
- Chammem, H.; Antonielli, L.; Nesler, A.; Pindo, M.; Pertot, I. Effect of a Wood-Based Carrier of Trichoderma atroviride SC1 on the Microorganisms of the Soil. J. Fungi 2021, 7, 751. [Google Scholar] [CrossRef] [PubMed]
- Muter, O.; Grantina-Ievina, L.; Makarenkova, G.; Vecstaudza, D.; Strikauska, S.; Selga, T.; Kasparinskis, R.; Stelmahere, S.; Steiner, C. Effect of Biochar and Trichoderma Application on Fungal Diversity and Growth of Zea Mays in a Sandy Loam Soil. Environ. Exp. Biol. 2017, 15, 289–296. [Google Scholar] [CrossRef]
- De Jaeger, N.; de la Providencia, I.E.; Rouhier, H.; Declerck, S. Co-entrapment of Trichoderma harzianum and Glomus Sp. within Alginate Beads: Impact on the Arbuscular Mycorrhizal Fungi Life Cycle. J. Appl. Microbiol. 2011, 111, 125–135. [Google Scholar] [CrossRef]
- Rudresh, D.L.; Shivaprakash, M.K.; Prasad, R.D. Effect of Combined Application of Rhizobium, Phosphate Solubilizing Bacterium and Trichoderma Spp. on Growth, Nutrient Uptake and Yield of Chickpea (Cicer aritenium L.). Appl. Soil Ecol. 2005, 28, 139–146. [Google Scholar] [CrossRef]
- Öğüt, M.; Akdağ, C.; Düzdemir, O.; Sakin, M.A. Single and Double Inoculation with Azospirillum/Trichoderma: The Effects on Dry Bean and Wheat. Biol. Fertil. Soils 2005, 41, 262–272. [Google Scholar] [CrossRef]
- Chaudhary, T.; Dixit, M.; Gera, R.; Shukla, A.; Prakash, A.; Gupta, G.; Shukla, P. Techniques for Improving Formulations of Bioinoculants. 3 Biotech 2020, 10, 199. [Google Scholar] [CrossRef]
- Santos, M.S.; Nogueira, M.A.; Hungria, M. Microbial Inoculants: Reviewing the Past, Discussing the Present and Previewing an Outstanding Future for the Use of Beneficial Bacteria in Agriculture. AMB Express 2019, 9, 205. [Google Scholar] [CrossRef]
- Kitir, N.; Yildirim, E.; Şahin, Ü.; Turan, M.; Ekinci, M.; Ors, S.; Kul, R.; Ünlü, H.; Ünlü, H. Peat Use in Horticulture. Peat 2018, 76–79. [Google Scholar] [CrossRef]
- Suherah; Kuswinanti, T.; Rosmana, A.; Rasyid, B. The Effect of Organic Medium Use in Formulation of Trichoderma harzianum and Pleurotus ostreatus in Viability and Decomposition of Cacao Pod Husks Waste. Pak. J. Biotechnol. 2018, 15, 95–100. [Google Scholar]
- Unsoed, P.; As, Y.; Sumadi, S.; Simarmata, T. Viability of Trichoderma harzianum Grown on Different Carrier Formulation. KnE Life Sci. 2017, 2, 95–101. [Google Scholar] [CrossRef]
- Nikolajeva, V.; Petrina, Z.; Vulfa, L.; Alksne, L.; Eze, D.; Grantina, L.; Gaitnieks, T.; Lielpetere, A. Growth and Antagonism of Trichoderma Spp. and Conifer Pathogen Heterobasidion annosum Sl In Vitro at Different Temperatures. Adv. Microbiol. 2012, 2, 295. [Google Scholar] [CrossRef]
- Senkovs, M.; Dzierkale, M.T.; Rimkus, A.; Grigs, O.; Nikolajeva, V. Application of a Posttreatment to Improve the Viability and Antifungal Activity of Trichoderma asperellum Biomass Obtained in a Bioreactor during Submerged Cultivation. Biology 2022, 11, 1610. [Google Scholar] [CrossRef] [PubMed]
- Singh, P.C.; Nautiyal, C.S. A Novel Method to Prepare Concentrated Conidial Biomass Formulation of Trichoderma harzianum for Seed Application. J. Appl. Microbiol. 2012, 113, 1442–1450. [Google Scholar] [CrossRef]
- Schubert, M. In Vitro und Ad Planta Studien Zum Einsatz von Trichoderma-Arten Für Die Biologische Kontrolle Holz Abbauender Pilze an Bäumen. Ph.D. Thesis, Albert-Ludwigs-Universität, Freiburg im Breisgau, Germany, 2006. [Google Scholar]
- Andrés, P.A.; Alejandra, P.M.; Benedicto, M.C.; Nahuel, R.I.; Clara, B.M. A Comparative Study of Different Strains of Trichoderma under Different Conditions of Temperature and PH for the Control of Rhizoctonia Solani. Agric. Sci. 2022, 13, 702–714. [Google Scholar] [CrossRef]
- Braga, G.U.L.; Rangel, D.E.N.; Fernandes, É.K.K.; Flint, S.D.; Roberts, D.W. Molecular and Physiological Effects of Environmental UV Radiation on Fungal Conidia. Curr. Genet. 2015, 61, 405–425. [Google Scholar] [CrossRef]
- Singh, V.; Keswani, C.; Ray, S.; Upadhyay, R.S.; Singh, D.P.; Prabha, R.; Sarma, B.K.; Singh, H.B. Isolation and Screening of High Salinity Tolerant Trichoderma Spp. with Plant Growth Property and Antagonistic Activity against Various Soilborne Phytopathogens. Arch. Phytopathol. Plant Prot. 2019, 52, 667–680. [Google Scholar] [CrossRef]
- Escudero-Leyva, E.; Alfaro-Vargas, P.; Muñoz-Arrieta, R.; Charpentier-Alfaro, C.; Granados-Montero, M.D.; Valverde-Madrigal, K.S.; Pérez-Villanueva, M.; Méndez-Rivera, M.; Rodríguez-Rodríguez, C.E.; Chaverri, P.; et al. Tolerance and Biological Removal of Fungicides by Trichoderma Species Isolated From the Endosphere of Wild Rubiaceae Plants. Front. Agron. 2022, 3, 117. [Google Scholar] [CrossRef]
- Jangir, M.; Sharma, S.; Sharma, S. Non-Target Effects of Trichoderma on Plants and Soil Microbial Communities. In Plant Microbe Interface; Varma, A., Tripathi, S., Prasad, R., Eds.; Springer International Publishing: Cham, Switzerland, 2019; pp. 239–251. ISBN 978-3-030-19831-2. [Google Scholar]
- Hoitink, H.; Boehm, M. Biocontrol within the Context of Soil Microbial Communities: A Substrate-Dependent Phenomenon. Annu. Rev. Phytopathol. 1999, 37, 427–446. [Google Scholar] [CrossRef]
- Krause, M.S.; Madden, L.V.; Hoitink, H.A.J. Effect of Potting Mix Microbial Carrying Capacity on Biological Control of Rhizoctonia Damping-Off of Radish and Rhizoctonia Crown and Root Rot of Poinsettia. Phytopathology 2001, 91, 1116–1123. [Google Scholar] [CrossRef]
- Heiberg, N.; Green, H.; Jensen, D.F. Population Growths and Survival of Trichoderma harzianum and Trichoderma virens in Sphagnum Peat. In Monitoring Antagonistic Fungi Deliberately Released into the Environment; Jensen, D.F., Jansson, H.-B., Tronsmo, A., Eds.; Springer: Dordrecht, The Netherlands, 1996; pp. 25–31. ISBN 978-94-009-1698-2. [Google Scholar] [CrossRef]
- Kredics, L.; Manczinger, L.; Antal, Z.; Pénzes, Z.; Szekeres, A.; Kevei, F.; Nagy, E. In Vitro Water Activity and PH Dependence of Mycelial Growth and Extracellular Enzyme Activities of Trichoderma Strains with Biocontrol Potential. J. Appl. Microbiol. 2004, 96, 491–498. [Google Scholar] [CrossRef]

| Medium | Dry Weight, % |
|---|---|
| M1 (MT1) | 91 ± 35 (100 ± 13) |
| M2 (MT2) | 50 ± 18 (77 ± 10) |
| M3 (MT3) | 35 ± 18 (24 ± 7) |
| M4 (MT4) | 56 ± 15 (78 ± 7) |
| Medium | Dry Weight, % |
|---|---|
| M1 (MT1) | 51 ± 4 (100 ± 10) |
| M2 (MT2) | 70 ± 3 (76 ± 3) |
| M3 (MT3) | 43 ± 5 (55 ± 5) |
| M4 (MT4) | 30 ± 5 (42 ± 6) |
Disclaimer/Publisher’s Note: The statements, opinions and data contained in all publications are solely those of the individual author(s) and contributor(s) and not of MDPI and/or the editor(s). MDPI and/or the editor(s) disclaim responsibility for any injury to people or property resulting from any ideas, methods, instructions or products referred to in the content. |
© 2023 by the authors. Licensee MDPI, Basel, Switzerland. This article is an open access article distributed under the terms and conditions of the Creative Commons Attribution (CC BY) license (https://creativecommons.org/licenses/by/4.0/).
Share and Cite
Rimkus, A.; Namina, A.; Dzierkale, M.T.; Grigs, O.; Senkovs, M.; Larsson, S. Impact of Growth Conditions on the Viability of Trichoderma asperellum during Storage. Microorganisms 2023, 11, 1084. https://doi.org/10.3390/microorganisms11041084
Rimkus A, Namina A, Dzierkale MT, Grigs O, Senkovs M, Larsson S. Impact of Growth Conditions on the Viability of Trichoderma asperellum during Storage. Microorganisms. 2023; 11(4):1084. https://doi.org/10.3390/microorganisms11041084
Chicago/Turabian StyleRimkus, Alina, Agne Namina, Marija Tereze Dzierkale, Oskars Grigs, Maris Senkovs, and Simona Larsson. 2023. "Impact of Growth Conditions on the Viability of Trichoderma asperellum during Storage" Microorganisms 11, no. 4: 1084. https://doi.org/10.3390/microorganisms11041084
APA StyleRimkus, A., Namina, A., Dzierkale, M. T., Grigs, O., Senkovs, M., & Larsson, S. (2023). Impact of Growth Conditions on the Viability of Trichoderma asperellum during Storage. Microorganisms, 11(4), 1084. https://doi.org/10.3390/microorganisms11041084

